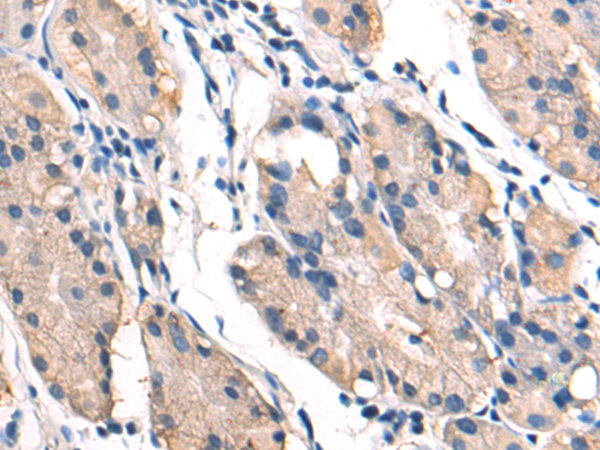

-
分类: 科研抗体货号: P04303别名: BMP9; HHT5; BMP-9应用: WB,IHC反应种属: Human, Mouse
-
分类: 科研抗体货号: P04351别名:应用: IHC反应种属: Human
-
分类: 科研抗体货号: P04298别名: CL1; DCLK; CLICK1; DCDC3A; DCAMKL1应用: WB反应种属: Human, Mouse
-
分类: 科研抗体货号: P04323别名: C17orf71应用: IHC反应种属: Human, Mouse
-
分类: 科研抗体货号: P04344别名: pf16; Repro-SA-1应用: WB反应种属: Human, Mouse
-
分类: 科研抗体货号: P04322别名: APH; OPH; AARE; ACPH; D3S48E; D3F15S2; DNF15S2应用: WB,IHC反应种属: Human, Mouse, Rat
-
分类: 科研抗体货号: P04340别名: MEMD; CD166应用: WB,IHC反应种属: Human, Mouse, Rat
-
分类: 科研抗体货号: P04378别名: p52; p100; H2TF1; LYT10; CVID10; LYT-10; NF-kB2; p49/p100应用: WB,IHC反应种属: Human, Mouse
-
分类: 科研抗体货号: P04339别名: M130; MM130应用: IHC反应种属: Human
-
分类: 科研抗体货号: P04377别名: NFBD1应用: IHC反应种属: Human

鄂公网安备42018502007531号
鄂公网安备42018502007531号

